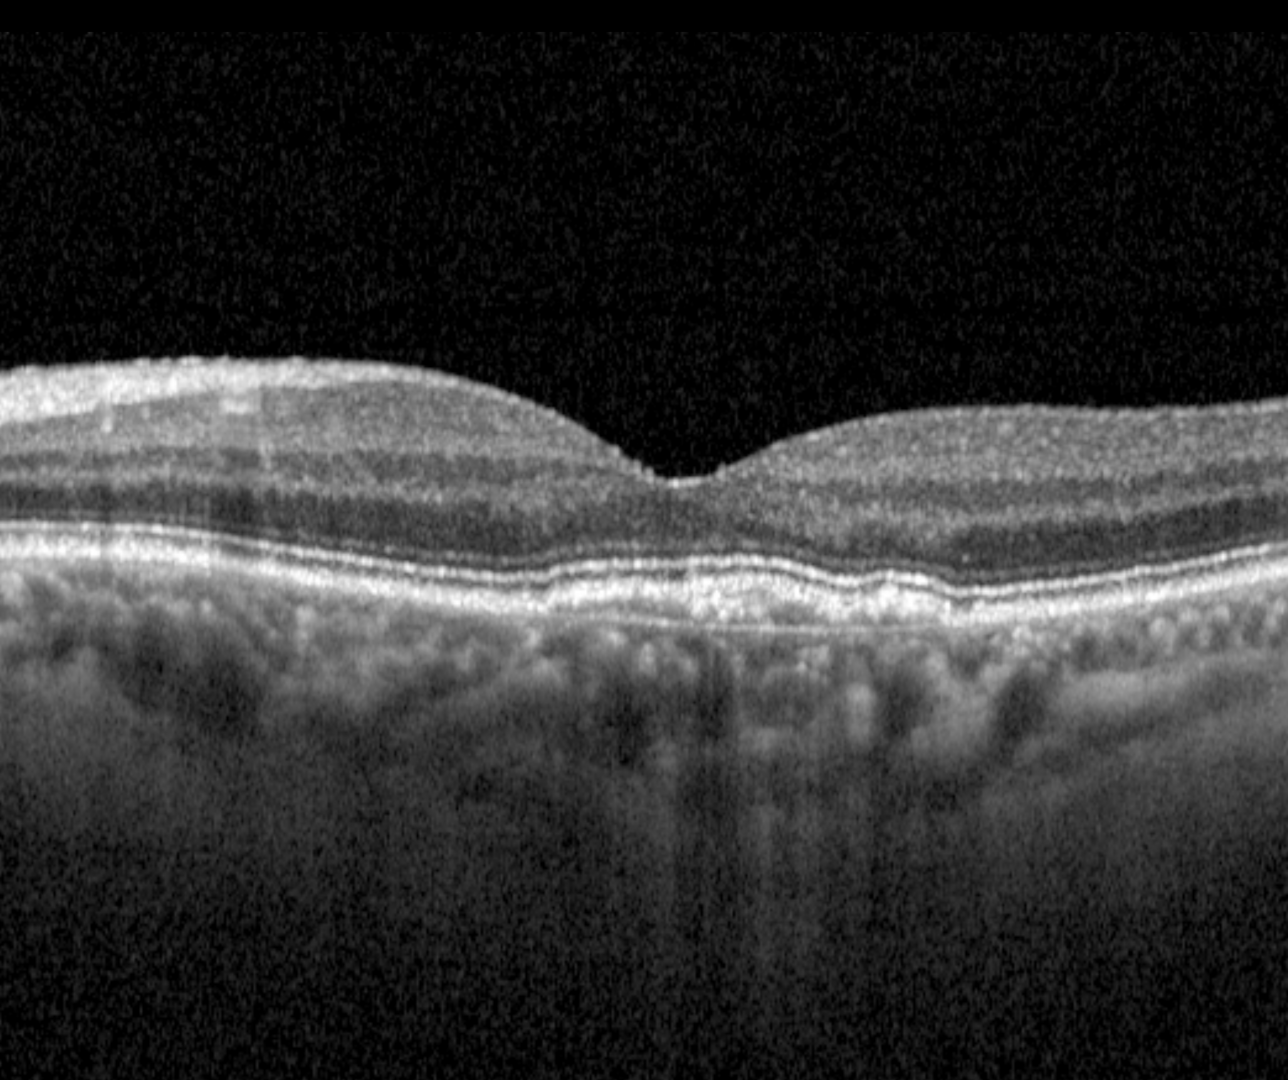

Overview
Pachychoroid neovasculopathy (PNV) is characterised by the presence of type 1 choroidal neovascularization overlying pachychoroid disease changes. It is thought to develop secondary to pachychoroid pigment epitheliopathy (PPE) or central serous chorioretinopathy (CSCR) and can progress to polypoidal choroidal vasculopathy (PCV) with the development of polypoidal lesions.
PCV may be associated with blur and/or metamorphopsia.
Colour fundus photographs usually show mild pigmentary changes at the macula.
OCT imaging typically shows a shallow irregular PED, also known as the double-layer sign. The sign is characterized by two hyper-reflective bands, where the upper band represents the RPE and the lower band represents Bruch’s membrane. The material residing in between these two hyper-reflective layers may represent choroidal neovascularization.
OCT angiography shows a tangled network of flow signal that coincides with the double-layer sign on structural OCT scans.
Case Examples
-
Case 1
A 71-year-old Caucasian female with best-corrected visual acuity of 6/9.5 (20/32) in the left.
-
Case 2
A 58-year-old Middle Eastern male with best-corrected visual acuity in the left eye of 6/9.5 (20/32). He reported waviness both superior and inferior to the fixation on Amsler grid testing when viewed with the left eye.
-
Case 3
A 71 year old Asian male with visual acuity of 6/7.5 (20/25) in the left eye. He reports good general health and takes no medications.
Differential Diagnosis
References
Borooah, S, Sim, P.Y, Phatak, S, Moraes, G, Wu, C.Y, Cheung, CMG., Pal, B, Bujarborua, D. (2020), Pachychoroid spectrum disease. Acta Ophthalmol.
Cheung, CMG, Lee, WK, Koizumi, H. et al. Pachychoroid disease. Eye 33, 14–33 (2019).


